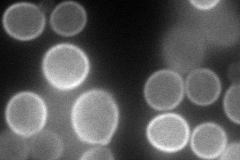
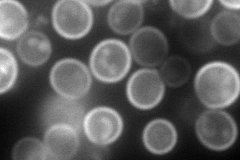
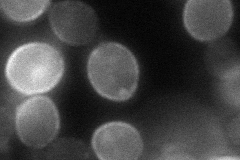
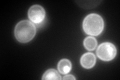

View description
Hexose transporter with moderate affinity for glucose, induced in the presence of non-fermentable carbon sources, induced by a decrease in growth rate, contains an extended N-terminal domain relative to other HXTs
Localization:
Intensity:
Fold change:
Significance:
-
C’ GFP library in SD

cell periphery44.68 -
N' NOP1pr-GFP in SD
cell periphery145.328 -
N' TEF2pr-mCherry in SD
cell periphery,vacuole234.406 -
N' NATIVEpr-GFP in SD

cell periphery18.4341 -
N' TEF2pr-VC and Cyto-VN in SD
cell periphery52.8853 -
C’ GFP library in SD+DTT

cell periphery71.071.59Yes -
C’ GFP library in SD+H2O2

cell peripheryN/AN/ANo -
C’ GFP library in Starvation Media
vacuole, cell peripheryN/AN/AYes -
C’ GFP library on the background of Pup2-DaMP

cell periphery -
C’ GFP library on the background of CCT mutant

cell periphery37.56290.840452No
